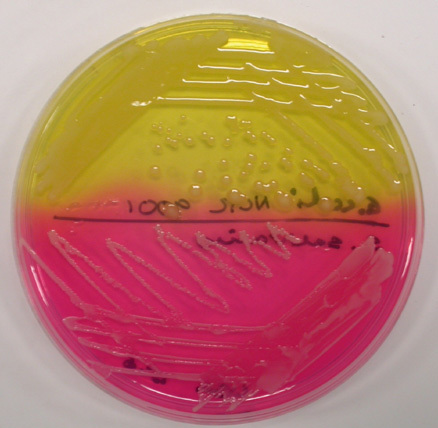

Obligate aerobes?
(growth only in the top portion of tube where O2 is) Bacteria that must have oxygen for survival
Facultative anaerobes?
(Uneven distribution of growth from top to bottom more at top) -Prefer to utilize oxygen, but can also use sources as nitrate for anaerobic respiration.
Microaerophiles?
Prefer conditions with lowered oxygen content and usually increased levels of CO2.
Thioglycollate?
Supports all types of bacterial growth. Suggest which type of environment a bacteria favors.
Reazurin?
A indicator that turns pink in the presence of oxygen. Seen at the upper portion of the test tube.
Gas-Pack Jars?
These jars provide a completely anaerobic environment. With a indicator for oxygen (blue= + for oxygen)
obligate anaerobes?
(Absence of growth in the top portion of broth) - Dies where O2 is
Aerotolerant anaerobes?
(Uniform growth from top to bottom ) Oxygen has no effect.
What type of growth is seen?

Obligate aerobe
What type of growth is seen?

Aerotolerant anaerobe
What type of growth is seen?

Facultative anaerobe
What type of growth is seen?

Microaerophiles
Seen at and right below the pink oxygen indicator line
*USE CAUTION*
easy to mess up
Candle Jar is used for what?
To increase carbon dioxide levels and to decrease oxygen. These are used best with Microaerophiles.
Mueller-Hinton agar
(MHA)
Used for?
To prevent inhibition of some antibiotics
Stapylococci and Streptococci are referred to as?
They are gram?
and usually have a shape of?
Pyogenic (pus-forming)
Gram +
Cocci
Staph or Strep?
How can you tell?

Staphylococci
They divide in more than one plane forming irregular clusters.
Staphylococcus or Streptococcus?
How can you tell?

Streptococci
They divide to form long chains
What type of enviornment do Streptococci perfer to live in?
Microaerophilic
Coagulase test
checks?
If the bacteria have the enzyme “Coagulase” which allows the bacteria to form clots from the fibrin in the blood.
What test is this?
The purpose?
What did it check?
Mannitol Salt agar
Differential test (Produce observable differences)
*Salt inhibits many bacteria, fernmentation of the mannitol will cause the medium to become acid and color change to yellow.
Indicator-phenol
The Bile esculin test?
Why would you use this test?
Positive result?
Identifies bacteria able to hydrolyze esculin in the presence of bile.
Used for a presumtive identification of group D streptococci and enterococci (both +)
After 72 hours of incubation if more than half of tube is black then +
CAMP Test: Used for?
Positive result?
Used for presumptive identification of group B streptococcus (Strep Agalactiae) the only beta-hemolytic strep that gives (+)
Positive result- See a arrowhead hemolysis between the junction of growth of S. aureus and group B strep.
Enterobacteriaceae family
characteristics?
Gram Negative, non-spore forming, facultatively anaerobic bacilli or coccobacilli
6.5% NaCl Broth
Salt Tolerance Test
Used for?
Separates Enterococcus from streptococcus
Positive result gives Enterococcus Group D
(Prelimarary test)


